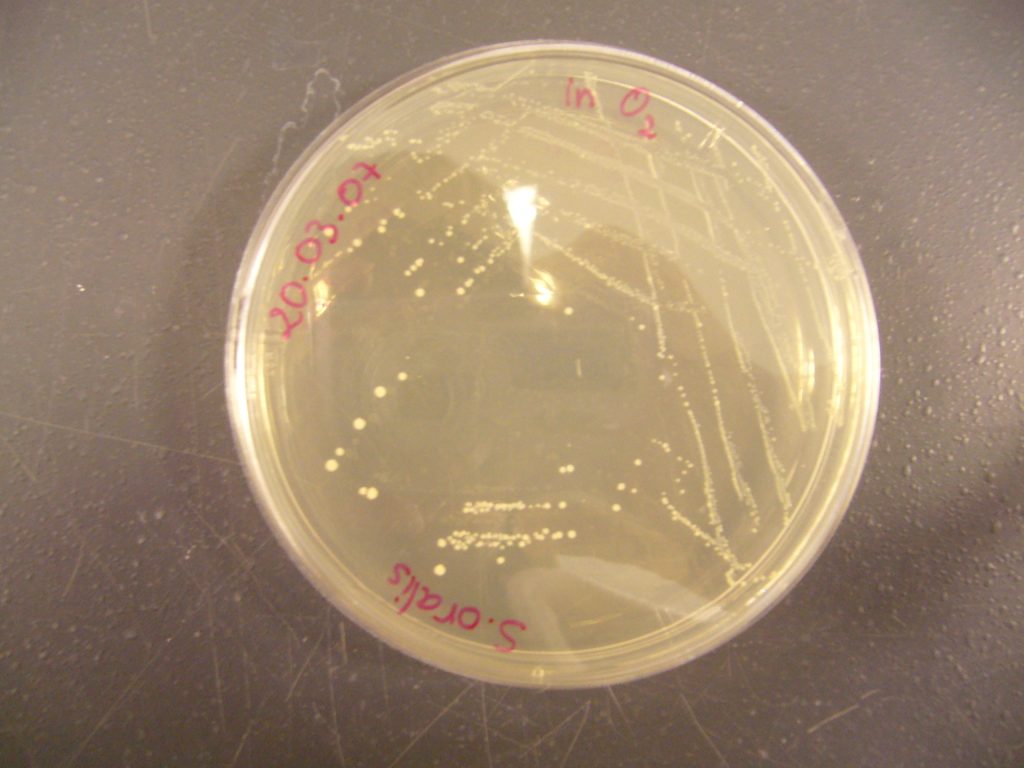
Coltura di S. oralis - Foto Wikimedia Commons @Djihed

Everest, i microbi emessi con gli starnuti sopravvivono nella Zona della Morte
Zona della Morte, “Death Zone”. Questa l’espressione utilizzata per indicare le porzioni delle vette più alte del mondo, oltre quota 7600-8000 metri, in cui le condizioni ambientali si fanno così estreme da non consentire la sopravvivenza dell’essere umano. Una zona in cui, a causa della percentuale estremamente bassa di ossigeno (circa un terzo della percentuale presente al livello del mare) il nostro organismo, per quanto acclimatato, inizia per l’appunto a morire in conseguenza dell’ipossia cui va incontro. Ebbene, secondo nuove ricerche realizzate sull’Everest, c’è una “parte di noi” che nella Zona della Morte sopravvive senza problemi: sono i microbi immessi nell’aria sottile attraverso gli starnuti.
Le comunità microbiche degli ambienti alpini, ovvero posizionati al di sopra di una quota di 7500 metri, non sono stati studiati finora in maniera dettagliata per evidenti limiti strumentali. Bisogna realizzare campionamenti di suolo “estremi”, per cui è necessario disporre di competenze alpinistiche ma anche essere in grado di seguire degli specifici protocolli di raccolta che consentano le successive analisi del campione. Lo studio “Genetic analysis of the frozen microbiome at 7900 m a.s.l., on the South Col of Sagarmatha (Mount Everest)”, pubblicato sulla rivista scientifica Arctic, Antarctic, and Alpine Research, ha previsto la realizzazione di campionamenti eccezionali, al Colle Sud dell’Everest, dunque a quota pari a circa 7900 metri, nel tentativo di fornire un identikit di quali batteri siano presenti a tale quota, e cercare di ricostruirne la storia: come siano arrivati lì, come possano sopravvivere e restare attivi in condizioni ambientali estreme. A tale scopo sono stati realizzati sequenziamenti genetici attraverso approcci “di nuova generazione”.
Microrganismi d’alta quota
L’alta quota, anche nel mondo dei microrganismi, non è per tutti. Studi finora realizzati, ad esempio, sulle montagne transantartiche, hanno evidenziato come in condizioni estreme (altissima quota, bassa percentuale di ossigeno, bassa temperatura) la biodiversità risulti limitata rispetto che alle quote più basse. Le comunità microbiche appaiono in sintesi meno diversificate e più lente nell’accrescimento. Anche l’identità e la funzione dei microrganismi possono cambiare all’aumentare della quota. In Himalaya si attesta un dominio dei funghi a una quota di 3.000 – 3.500 m, mentre a quote superiori si riscontra una maggiore presenza di Archea che ossidano l’ammoniaca (tra 4.000 e 4.500 m) e batteri ossidanti ammoniaca fino a 6.500 m. Nota è anche la presenza di microrganismi fotosintetici in aree periglaciali dell’Himalaya oltre i 5.500 metri. Salendo a quote superiori, oltre i 7.000 metri, i pochi campioni finora utilizzati hanno fornito l’immagine di ambienti dominati da un piccolo numero di taxa estremofili in grado di restare attivi, insomma di vivere tranquilli a tali quote. Accanto a questi si ritrovano microrganismi “non locali” e decisamente non evoluti per sopravvivere a tali quote, trasportati dal vento o “trasportati e abbandonati” dagli alpinisti. In questo caso si tratta di microrganismi in grado sì di sopravvivere ma restando inattivi. Con riferimento specifico all’Everest, comunità microbiche sono state analizzate nel corso dei decenni fino a 7500 metri di quota. Lo studio ora realizzato al Campo IV risulta un unicum nel suo genere.
Chi vive a 7900 metri di quota?
I campionamenti sono stati realizzati, come si diceva, al Colle Sud, dove le temperature raggiungono regolarmente i -33°C con una pressione atmosferica pari a un terzo di quella al livello del mare, e dove il vento si fa sentire bene (velocità massima 66,5 m/s) e vi è anche un forte irraggiamento solare. Nonostante l’estrema elevazione e la corrispondente elevata radiazione UV, basse temperature e minore disponibilità di ossigeno, il team di ricerca statunitense ha trovato un bel po’ di piccoli abitanti al Colle Sud, un mix diversificato di batteri, protisti e funghi, “inclusi una combinazione di taxa cosmopoliti”, come scrivono gli autori “e microrganismi specializzati spesso riscontrati a quote elevate, come i generi Modestobacter e Naganishia”. Tra i microrganismi trasportati dall’uomo sono stati riscontrati stafilococchi e streptococchi, in particolare lo S. oralis, che abita il nostro cavo orale.
C’è da preoccuparsi?
La contaminazione che stiamo attuando da decenni nella Zona della Morte, può rappresentare una fonte di preoccupazione per il futuro? Gli esperti sottolineano che “tutti o la maggior parte degli organismi trovati al Colle Sud in questo studio raramente, se non mai, siano in grado di accrescersi. Gli organismi che abbiamo isolato e coltivato probabilmente sono usciti dalla dormienza solo a causa delle condizioni meno estreme dell’ambiente di laboratorio.”
Il forte irraggiamento solare del Colle Sud può determinare uno scioglimento dei ghiacci, e la presenza di acqua libera potrebbe determinare la riattivazione metabolica dei microbi, ma “non è chiaro se quest’acqua libera sarebbe sufficiente per sostenere brevi periodi di crescita microbica, dato che le temperature dell’aria raramente superano i -10°C a quote così elevate sul Monte Everest”. “Tuttavia – prosegue il team – precedenti lavori ad alta quota nell’Atacama hanno dimostrato che anche quando le temperature dell’aria sono inferiori a -10°C (a 2 m di altezza dal suolo), le temperature superficiali del suolo possono raggiungere +5°C a causa dell’intensa insolazione.”
Lo scenario più probabile è che il Colle Sud e altri ambienti ad altitudini estremamente elevate possano fungere da freezer. Ovviamente, con uno sguardo al futuro, consci del cambiamento climatico in atto, gli scienziati non escludono che gli organismi che non sono attivi in situ ora possano diventare attivi in futuro.

Sul fatto che i batteri possano restare vivi in ambienti estremi non è una novità. Ad esempio, quando gli astronauti dell’Apollo 12 riportarono sulla terra parti della sonda Surveyor inviata nello stesso sito del loro atterraggio due anni prima, una volta analizzati al rientro sulla Terra scoprirono sugli stessi ancora in vita dei batteri da starnuto che si erano depositati sulla sonda prima del suo invio sulla Luna. E parliamo di ambiente privo di atmosfera e con temperature che oscillano da +150° al sole e -150° all’ombra. Direi che il Colle sud è molto più vivibile.
Quello che invece sarebbe interessante sapere è se la neve che contiene questi batteri, prelevata e sciolta per farsi un te, possa risultare dannosa per l’organismo o no.